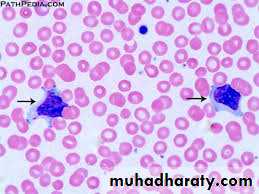
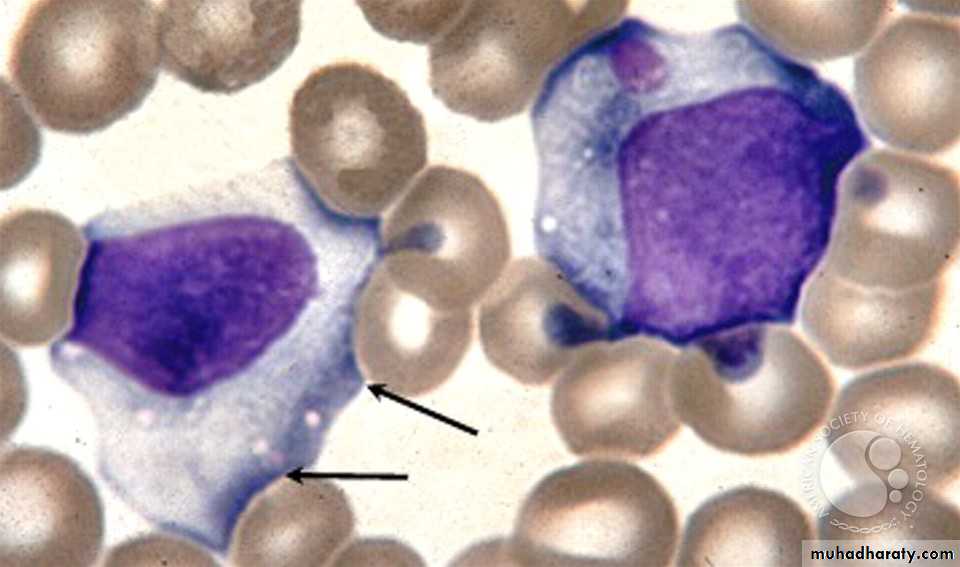

poliomyelitis
It is one of the causes of acute flaccid paralysis syndrome causing paralysis of the muscles of the limbs caused by; either wild strain PV , or by oral vaccine induced virus. It is transmitted from person to person via feco-oral route.poliovirus is RNA enterovirus.
Patterns of polio infection
Basically three forms of infectionA. minor illness (abortive) not affecting muscle power, presents as flu like fever, sore throat ,vomiting.95%
B. aseptic meningitis as headache, neck stiffness,fever. 2-3% of cases, no paralysis
C. paralytic form 1% cause acute flaccid paralysis of the limbs , even bulbar or bulbospinal paralysis.
Diagnosis and differential diagnosis
Acute flaccid paralysis syndrome defined as Any acute limping less than 15 days onset with weakness and absent reflexes should consider acute flaccid paralysis AFP syndrom (polio,GB,TM) so send stool sample to the preventive medical center for polio virus detection by; culture ,and by PCR to detect type of polio virus.Guillain-Barre syndrome GB is another cause for AFP ,so it should be excluded . In GB syndrome is acute ascending bilateral symmetrical paralysis,while in polio it is unilateral paralysis.
Transverse myelitis TM also should be excluded causing paraplegia.
EPSTEIN-BARR VIRUSINFECTION
INFECTIOUS MONONUCLEOSIS is the best known clinical syndrome caused mostly by Epstein-Barr virus (EBV).it also called glandular fever. The virus is related to herpes group; DNA virus. It causes 90% of infectious mononucleosis syndrome.Other 10% caused by CMV and Toxoplasmosis, even adenovirus.
Clinical picture
The virus transmitted by saliva. It is DNA herpes virus.
Incubation period 1-2 months. Presentation as triad of fever for 1-2 weeks with lymphadenopathy of the back of the neck, axilla, groin, and sore throat simulate exactly follicular tonsillitis due to streptococcal infection. Hepatosplenomegaly may be found They regress in 2-3 weeks. Fever resolve in 1week. Most of cases develops body maculopapular rash when ampicillin or amoxicillin are given.
Spontaneous improvement within 2-4 weeks without special treatment.
LYMPHADENOPATHY in IMN
Rash of ampicillin in IMN,TONSILLITIS
Atypical lymphocytes
large cytoplasm,nucleoli in the nucleus, indented by surrounding RBCs
complications
Splenic rupture if exposed to trauma, in 0.5%of cases.
Other complications are rare includes; hepatitis and jaundice, encephalitis ,Guaillain-barre syndrome, hemolytic anemia,, thrombocytopenia, carditis, Burkett lymphoma, and upper air way obstruction due to oropharyngeal swelling.
diagnosis
CBC shows high leukocytosis mainly due to lymphocytosis; with 20-40% of lymphocyte count are atypical (reactive cells) seen in the blood film Throat swab culture ; negative for strept.bact,Definite diagnosis for EBV infection is to detect EBV- IgM antibody in the serum by the lab.
Differential diagnosis of EBV infection are CMV, adenovirus,, and toxoplasmosis, all these shows lymphocytosis, and even atypical lymphocytes, but negative EBV serology tests.